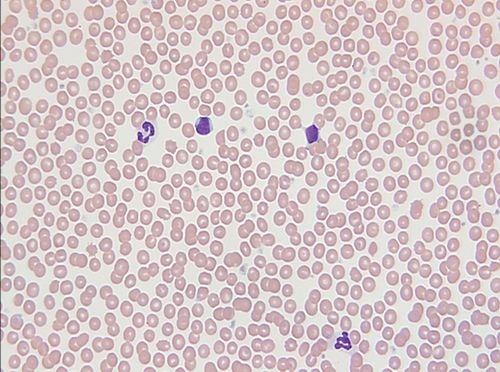
Haematológiai laboratóriumi vizsgálatokról

Haematológiai laboratóriumi vizsgálatokról
A különböző sejtes elemek alaki vizsgálatának igen nagy jelentősége van. A számszerű értékeken túl meg kell nézni, milyen a sejtes alakja, nagysága, érettsége, festődése, tartalmaznak-e idegen anyagokat. Az előbbiekre a mennyiségi vérkép, az utóbbiakra a minőségi vérkép ad felvilágosítást.A haemoglobin- vizsgálat tájékoztat a szervezet oxigénellátásának mértékéről(oxigénszállítási képességéről). Ha a haemoglobinérték megfelel a vörösvérsejtszámnak, normochrom, ha annál kisebb, hypochrom. ha nagyobb, hyperchrom vörösvérsejtekről beszélünk.A normális nagyságú vörösvérsejt a normocyta, a kisebb a microcyta, a nagyobb a macrocyta.Ha a vörösvérsejtek a normálisnál vastagabbak, alakjuk a gömbéhez közeledik, sphaerocytosisnak nevezik. Ha a vörösvérsejtek különböző nagyságúak, a jelenséget poikilocytosisnak, ha különböző festődésűek, anisocytosisnak hívják.A haematocrit- érték a vörösvérsejtek és a plazma arányát mutatja. Az ujjbegyből vett vért centrifugálják, így olvasható le az az érték, amely a sejtek térfogatát jelzi. Ez az érték 40-45%. Újszülötteknél ennél valamivel magasabb, csecsemőkorban pedig kisebb. Változásából a vér felhígulására, ill. besűrűsödésére is lehet következtetni.A haemoglobin és a haematocrit viszonya fejezi ki a vörösvérsejtek átlagos haemoglobin- koncentrációját(rövidítve MCHC- ez az angol változat rövidítése), amely a vérszegénység vizsgálatakor az egyik legfontosabb mérőszám.Ezeket a vizsgálatokat korszerű automata sejtszámlálók segítségével rövid idő alatt, kevés vérből végzik.A csontvelővizsgálat a haematológiában alkalmazott diagnosztikus eljárás. A vér sejtes elemeinek összetételéről ad felvilágosítást. A sejtes elemek megfogyatkozása a csontvelőben képzési zavarra, felszaporodása kompenzáló túlműködésre, idegen anyagok megjelenése pedig rendszerbetegségre(daganat, tárolási betegség) utal. Ha fiatal, éretlen fehérvérsejtek jelennek meg és a normális alakok háttérbe szorulnak, leukémiára kell gondolni.Az újszülött vérmennyisége 90-100 ml/kg, azaz kb. 300 ml, amely egy éves korra kétszeresére nő. A koraszülötteknél 100-110 ml/kg-ra tehető. A későbbiekben 80ml/kg. Ismeretére transzfúzió esetén van szükség.A szerológiai vizsgálómódszerek segítségével olyan vérképzőszervi megbetegedéseket ismernek fel, amelyek szenzibilizálódás következményei. Ilyen pl. az Rh- és az ABO- összeférhetetlenségből adódó újszülöttkori súlyos sárgaság, az immunhaemolysticus anaemiák, stb.A pontos diagnózishoz speciális véralvadási laboratóriumban végeznek vizsgálatokat a kórházban végzettek mellett. Betegágy mellett a vérzési és alvadási idő, a thrombocytaszámolás, a retractio és a kapilláristörékenység vizsgálata történhet.A vérzési idő vizsgálata módosított Ivy- módszerrel: A vizsgálat menete: a felkarra helyezett vérnyomásmérőt 40Hgmm-re felpumpálva az alkar hajlító oldalán, előzetes fertőtlenítést követően, egymástól 1-1,5cm-re 3 sebzést ejtünk egy 3mm hosszú, heggyel rendelkező lándzsával. Vigyázni kell, hogy felületes véna ne sérüljön. A szúrásokból kibuggyanó vért félpercenként szűrőpapírral leitatjuk. A normál érték 6perc. Megnyúlt értéket mutat a thrombocyták hiánya és működési zavara esetén(az erek összehúzódási képességét, thrombocyta-dugó kialakulásához szükséges időt mutatja).A teljes vér alvadási idejét vénás vérből Wasserman-csőben, döntögetéssel végzik. Szobahőmérsékleten 10 percen belül teljes alvadás következik be. Pontosabb vizsgálat, ha a 37fokos vízfürdőben végezzük 2 csőben egyszerre. Hibás értéket adhat, ha a cső nem tiszta, vagy a vénából nyert vért nyomkodással sajtoljuk(szöveti thromboplasztin keveredhet bele). Nem eléggé érzékeny módszer, ezért olyan klinikai jeleket tapasztalva, amelyek alvadási zavar gyanúját keltik, feltétlenül speciális laboratóriumi vizsgálatokat kell igénybe venni(egyik módszere az óraüvegre cseppentett vér tűvel való kevergetése, és az idő figyelése, mikor jelenik meg az első fibrinszál-eközben mérik a szúrás helyén meddig áll fenn vérzés).Speciális véralvadási vizsgálatokhoz a vért rendszerint 1:10 citrátos higítással(korszerűen előre gyártott, ún. Vacutainer csőbe) veszik le, gondosan ügyelve, hogy a szöveti thromboplasztin ne keveredjen a vérhez. Ez a módszer azért is előnyös, mert csökkenti a fertőzésveszélyt, ezentúl a csőben lévő szívóhatás miatt a vénát nem kell pumpálni, a vér az alvadásgátlóval jobban keveredik. Az alvadékos vérminta véralvadási vizsgálatokra alkalmatlan. Ezért a csövet a vér levétele után gyengéden meg kell forgatni.Az előfázis zavarainak vizsgálatára szolgál a PTI(parciális thromboplasztin-idő). A prothrombin-thrombinná alakulásának vizsgálata a Quick-idő, s ennek a normálishoz viszonyított értéke a prothrombinszint(normálértéke:70-120%).A fibrinogén- fibrin átalakulás zavarairól a thrombinidő ad felvilágosítást.Ezeken kívül még számos vizsgálat segíti a vérzékenység diagnosztizálását.
Kapcsolódó fórumok:
- alvadékos vérminta
- haematocrit magas
- haematocrit jelentése
- alvadékos minta
- csontvelővizsgálat
- haematocrit alacsony
Hozzászólások (0)
Jelentkezz be, hogy hozzászólhass!
BejelentkezésMég nincs hozzászólás.
Legyél az első, aki hozzászól!